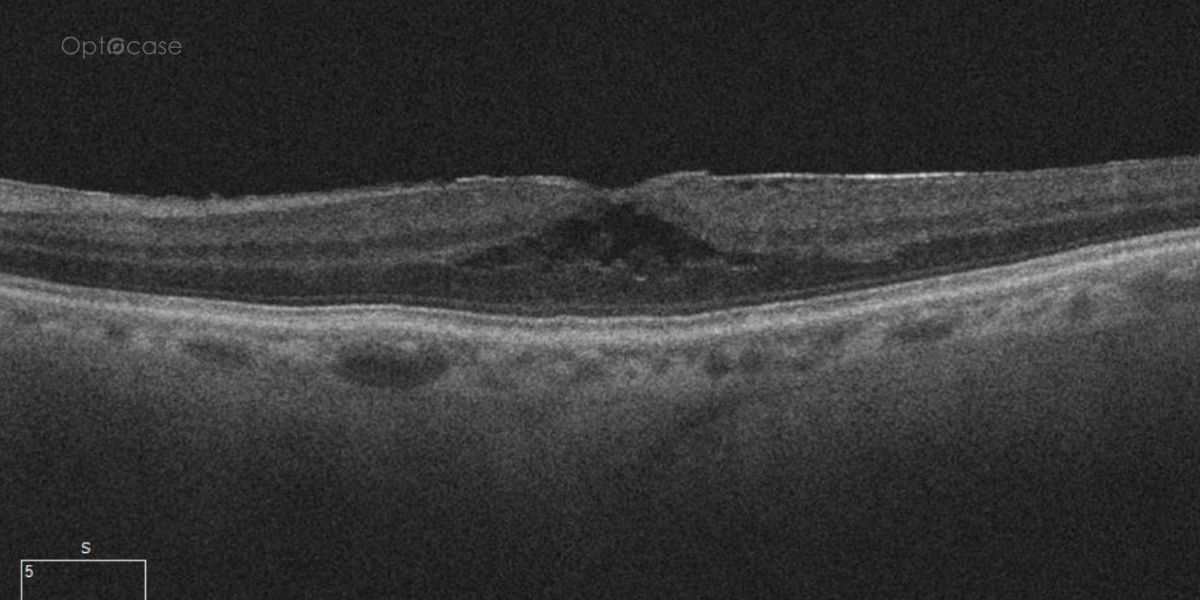
Tip #258

A 73-year-old presents with new distortion. Why?
Analysis
Here there is loss of the regular macular depression. There is a bright line present on the surface of the retina. In addition, there is separation of the retinal layers in the inner retina.
The patient was diagnosed with a schisis secondary to an epiretinal membrane. This complication is seen in over 50% of ERMs (video).
In this tip's accompanying 9 min. video, we'll review:
- The pathogenesis an epiretinal membrane
- A differential diagnosis of an intravitreal hyporeflective area
- Where the vitreous is adherent to the retina

OCT Tip
In any patient with intraretinal fluid consider the possibility of an epiretinal membrane causing a schisis.
Not receiving our tips yet? Subscribe to receive them straight to your inbox.